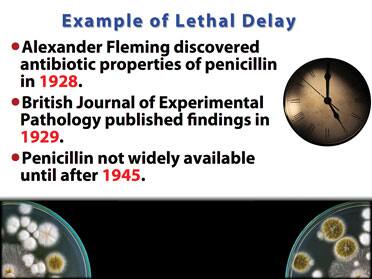
Image with Caption

Life Extension Magazine®

We made medical history at the inaugural Revolution against Aging and Death (RAADfest) conference held in August 2016.
For the first time, scientific methods to help enable older people to grow biologically younger were revealed.
RAADfest was the largest gathering of radical longevity enthusiasts ever.
Of the age reversal research projects that need outside funding, we’ve identified what appear to be the proverbial “low-hanging fruit.” This means these treatments offer strong potential for reversing human aging right now!
Our immediate goal is to expeditiously develop these therapies to provide an additional 20-30 years of healthy longevity to older individuals.
The reason this extra time is so critical is that within the next 20-30 years science may gain total control over pathologic aging processes.
This article contains Power Point slides demonstrating that biological age reversal is already occurring in proof-of-concept studies.
Based on the data you are about to see, millions of human lives may be spared.
We need to confirm these findings in larger population groups. Continued demonstration of biological age reversal will likely move these treatments into routine medical protocols for people over age 60.

There are five age-reversal projects that can be launched right now if funding becomes available.
What’s so tantalizing about these studies is that no new drug needs to be discovered to begin testing these therapies on older individuals.
The simplest human trial involves an FDA-approved drug called dasatinib that demonstrated profound age reversal effects in a mouse study published in 2015.
Just one dasatinib tablet taken for three consecutive weeks might induce systemic rejuvenating effects in people. There are several dasatinib doses we want to see tested along with other agents we think will work synergistically with this drug.
The cost of this drug is remarkably low since only three tablets might be needed to be taken every 5 or 10 years.


Growth Differentiation Factor 11 (GDF11)

GDF11 is a naturally occurring peptide that has the capacity to restore aging muscles, hearts, and brains in mice.
Researchers at Harvard (and other institutions) have shown it may induce significant age reversal effects.
GDF11 had never been tested in humans until a pioneering longevity enthusiast became patient zero on June 7, 2014.
About 20 volunteers are now self-experimenting and measuring biomarkers to determine GDF11’s effectiveness.
Power Point slides on pages 13 and 14 describe the rationale for using GDF11, its mechanisms of action, and the human age-reversal effects demonstrated so far.
Conclusion: The preliminary data from a cohort of humans self-experimenting with GDF11 indicate an urgent need for a controlled clinical trial to see if these age-reversal effects are reproducible among a larger group of individuals over age 55.







Young Stem Cell-Mobilized Plasma Transfer
The bone marrow of healthy 21-year-olds contains an abundance of functional stem cells, immune cells, and paracrine factors including plasma exosomes, proteins, and cytokines. Young blood also contains lots of GDF11.
Using an FDA-approved factor that mobilizes bone marrow and a proprietary protocol for its administration, rapid release of pro-youth factors is enhanced.
Through a process known as apheresis, these pro-youth factors can be harvested in the plasma from the young donors and then administered to older people with the objective of restoring healthy immune function along with systemic tissue regeneration and a reduction of frailty.
This study is to be conducted at the South Florida Bone Marrow/Stem Cell Institute in Boynton Beach, Florida. It plans to initially enroll about 30-50 study subjects who meet the eligibility criteria to receive the mobilized plasma from blood-matched healthy young donors. We also want to fund an analogous study protocol at the Young Blood Institute in San Francisco if funding becomes available.
The following slides describe the premise behind rejuvenating older individuals with stem cell-mobilized plasma from young persons.
Conclusion: There are several methods of delivering the benefits of young plasma exchanges to older individuals, but tightly controlled research must be done. We are looking at three research centers now to accelerate these programs. Financial support is urgently needed.

Thymic Regeneration

Immune senescence can be initiated by the atrophy of the thymus gland that begins near the time of puberty.
Thymic atrophy can be reversed in animals and in young HIV patients, but until recently this has only been documented once in a normal aging human.
Now, a human age-reversal trial with collaborators at Stanford University is underway using FDA-approved agents in a creative combination that has been shown to not only regenerate the thymus, but to improve blood markers indicative of healthier immune status. Safe rejuvenation of other organs may be possible as well.
Side effects have been minimal, and subjective responses have been positive. Spin-off applications of thymic regeneration technology include elimination of type I diabetes, autoimmune diseases, and transplant rejection.
The following slides describe the preliminary results shown in the initial study of 9 people aged 50-65 years.
Conclusion: These results indicate that immune senescence may already be reversible with the creative use of existing FDA-approved therapies. A larger study of older people utilizing a similar protocol is scheduled for 2017 if sufficient funding can be acquired. Those who reside in Southern California will find it more convenient to participate as study subjects.


The graph on this slide shows some of the devastating immune changes that occur during normal aging. In particular, a sharp decline in naïve T cells and overexpansion of defective CD8 cells reduces our ability to ward off new infections and malignancies.
The accumulation of memory cells results in many of them growing senescent, which contributes to the low-level chronic inflammation that impacts elderly people.
Immune senescence and ensuing inflammation can affect all of the body’s tissues, impacting not only immune functions, but also cognitive and cardiovascular health. Reversing immune senescence is critical to healthy longevity.





How Can This Research Be Funded?
Human studies are now ready to begin to confirm recent data showing meaningful reversal of pathological aging processes.
These clinical trials aim to alter older humans so that they function as much younger individuals.
Even modest success will result in a paradigm shift that will impart enormous societal benefits, such as sparing Medicare from insolvency.
We at Life Extension are not standing by while 5,000 Americans perish each day from age-related illnesses. Fortunately, we are no longer alone in wanting to accelerate the pace of human age-reversal research.
Joining us are physician-scientists who want to hurry up these technologies to keep people from “aging to death.”
The Power Point slides in this article represent a succinct overview of a myriad of age-reversal techniques that offer potential for quick clinical results. This means the therapy could be readily implemented to spare aging individuals from premature extinction.
While Life Extension is pushing these projects forward, we need financial help from our supporters.
We’ve created two dedicated organizations that will use donations and investments to accelerate human age-reversal research endeavors.
If any study is successful, it will be impossible to meet the demand that may occur as tens of millions of elderly individuals will clamor to get it. Think of the movie Cocoon.
Life Extension supporters will be given priority to these therapies whenever possible.
To invest in Age Reversal Therapeutics, Inc., a company dedicated to rapidly developing age-reversal therapies, log on to: AgingCure.com or call 1-866-554-7108 (24 hours).
You can also support this research by making a tax deductible donation to:
- Life Extension Society
- 3600 West Commercial Blvd.
- Ft. Lauderdale, FL 33309
(All donations to Life Extension Society will be used to fund human age-reversal research.) Those who want to invest in Age Reversal Therapeutics, Inc. after it becomes a Reg A company (that does not require investor accreditation) should indicate their interest by logging on to AgingCure.com.
Those who invest or donate might also be able to participate in these age-reversal clinical trials if they satisfy the study’s eligibility criteria.
If you have any questions on the scientific content of this article, please call a Life Extension® Wellness Specialist at 1-866-864-3027.
Important information
An investment in Age Reversal Therapeutics, Inc. (the “company”) may only be made in accordance with and following review of a confidential private placement memorandum. The information herein is not meant to replace or supplement the confidential private placement memorandum. This communication and any information herein does not constitute an offer to sell or the solicitation of an offer to purchase securities to any person in any jurisdiction. The securities to be issued in our rule 506(c) offering will not be registered under the Securities Act of 1933, as amended, or any other law or regulation, and only accredited investors, as defined in 17 C.F.R. 230.501(a), may purchase them.
Neither the U.S. Securities and Exchange Commission nor any state regulator or other regulatory body has approval, passed upon the merits of, or given its approval to, the securities, the terms of the offering, or the accuracy or completeness of any information related to an investment in the company.
No money or other consideration is being solicited for our regulation A+ offering at this time and if sent in to the company will not be accepted. No offer to buy securities in a regulation A+ offering of the company can be accepted and no part of the purchase price can be received until the company’s offering statement is qualified with the SEC. Any such offer to buy securities may be withdrawn or revoked, without obligation or commitment of any kind, at any time before notice of its acceptance given after the qualification date. Any indications of interest in the company’s offering involves no obligation or commitment of any kind.
The company is testing the waters under regulation a of the Securities Act of 1933, as amended. This process allows companies to determine whether there may be interest in an eventual offering of its securities. The company is not under any obligation to make an offering under regulation A. The company may choose to make an offering to some, but not all, of the people who indicate an interest in investing, and that offering may not be made under regulation A. If the company does go ahead with an offering under regulation A, it will only be able to make sales after it has filed an offering statement with the Securities and Exchange Commission (“SEC”) and only after the SEC has qualified such offering statement. The information in the offering statement will be more complete than the test-the-waters materials and could differ in important ways. You must read the offering statement filed with the SEC.

